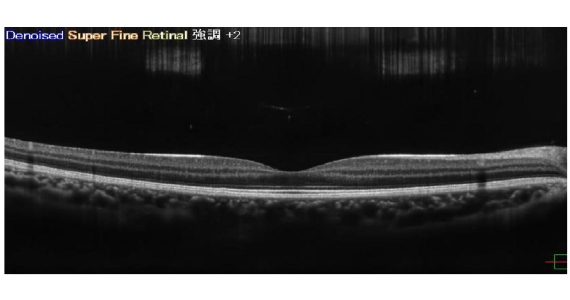
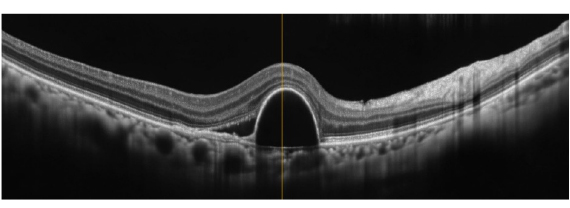
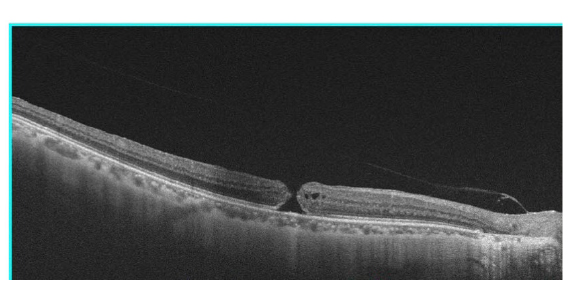

診療内容
人間ドック二次検診・学校検診
人間ドックで引っかかった場合は病気が隠れている可能性があります。当院で全て二次検査が可能です。
・視力低下と書いてあったら
視力低下には様々な病気が隠れていることがあります。矯正しても1.0の視力が出ない場合、左右で見てゆがんで見える場合、角膜の病気、水晶体の病気、眼底の病気、視神経の病気、脳の病気等さまざまな病気が隠れていることがあります。精密検査で眼や眼以外の大きな病気が見つかることがあります。一度眼科にて精密検査をお受けください。

・白内障疑いと書いてあったら
視力低下や眼底写真の写りが悪いと白内障疑いで引っかかることがあります。一度精密検査をお受けください。
水晶体は通常透明ですが

年齢と共に濁ってきます。
白内障は軽度なら経過を見ることがありますが、進行すると視力低下を来たし、免許が通らないといった結果になることもあります。点眼で進行を遅くできますが、根治治療は手術となります。当院は白内障手術も行っております。10分~15分位の局所麻酔による手術です。
・視神経乳頭陥凹拡大、網膜神経線維束欠損と書いてあったら
上記のように書いてあったら、それは緑内障等眼の神経の病気が隠れている可能性があります。正常の視神経の乳頭部分は若干のへこみがありますが、へこみが大きくなっている場合、脳にいく神経線維の束が痛んでいる事を示唆します。

写真ではこのように写ります。OCTという機器で測定すると網膜の厚みと視神経の状態を解析してくれるので神経が傷んでいる部分が一発で分かります。

視野検査をすると視野が欠けているかどうかがわかります。
視野検査をすると視野が欠け始めていました(下図の黒い部分)

このように人間ドックで緑内障が見つかることもあります。放置すると失明するため、点眼治療が必要となります。
・黄斑異常と書いてあったら
加齢黄斑変性症 黄斑浮腫 黄斑円孔、黄斑前膜など
黄斑部分は神経の集まっている場所です。ここが少しでも傷むと視力障害が出ることがあります。正常の黄斑部分は上記のようになっており少しへこんでいます。
加齢黄斑変性症
加齢黄斑変性症とは網膜の中心部分の黄斑という場所に出血やむくみが生じて視力が低下する病気の事です。喫煙や紫外線等がリスクを強めると言われております。サプリメントで加齢黄斑変性の発症リスクを下げる事が出来ます。また発症してしまったときは注射等の治療があります。
黄斑浮腫

黄斑部分という物をみる大事な部分が、糖尿病や網膜の静脈が詰まること等により腫れてしまうことがあります。通常へこんでいる黄斑部分が上図のように腫れてしまっています。
治療は原疾患(糖尿病や静脈が詰まる原因疾患)の治療や、眼科的には検査を行い詰まって血流の通っていない部分へのレーザー治療や腫れを引かせる注射等により視力回復や維持を目指します。
黄斑円孔
黄斑に孔が開くことがあります。ものを見る中心部分に孔があくので、ものがゆがんで見えたり、左右の物の大きさが違って見えたりします。両眼で見ると気づかない事もありますので見え方がおかしいと思ったら、左右それぞれで見てチェックしてください。OCTの検査で上の写真のように一発で診断が出来ます。治療は孔の開き具合にもよりますが基本は手術となります。手術は早ければ早いほど視力回復の可能性が高くなるので、ゆがみ等を感じたらすぐに眼科受診をして下さい。
黄斑前膜

黄斑部に膜が張ることがあります。ゆがんで見えたり、矯正視力が低下したら手術適応となります。自然には良くなりません。
・眼底出血と書いてあったら
糖尿病網膜症 網膜中心静脈閉塞症、正常眼圧緑内障、白血病等
正常網膜
出血やしみを認めません。

糖尿病
糖尿病網膜症
全体にしみや、
出血が見られます。

網膜中心静脈閉塞症
血管が詰まった
場所に出血が見られます。

網膜の静脈が詰まることにより、黄斑部分が腫れたり、悪い血管が生じて大出血を起こした結果視力障害が生じることがあります。
視神経乳頭近傍出血

乳頭近傍の出血により緑内障が見つかることもあります。
白血病等の血液疾患

眼底は直接血管を見ることが出来る場所です。網膜表層出血内に白色部分を認める(Roth班)があると、白血病などの血液疾患が見つかることがあります。
Scheie分類 HⅠ~Ⅳ SⅠ~Ⅳ
高血圧性の変化
| 高血圧性変化(H) | 動脈硬化性変化(S) | |
| 1期 | 軽度の動脈挟細化 | 軽度の血栓反射亢進と交叉現象 |
| 2期 | 中等度の動脈挟細化、口径不同 | 中等度の血栓反射亢進と交叉現象 |
| 3期 | 高度の動脈挟細化、網膜出血、軟性白斑、硬性白斑 | 高度の血栓反射亢進(銅線動脈)と交叉現象 |
| 4期 | 3期+乳頭浮腫 | 高度の血栓反射亢進(銀線動脈)と交叉現象 |
眼底は血管を直接観察できる場所です。
上の図を簡単に説明すると、血管の状態によって動脈硬化の具合と高血圧による具合を分類した物です。
このように人間ドックで行われている眼底カメラだけでもこれらの病気が早期に見つかることがあります。人間ドックで引っかかったら早めに眼科受診をして下さい。
3歳児検診・学校検診
学校検診でも視力低下や斜視、結膜炎などが見つかることがあります。遠視や斜視による弱視治療は成長期に治療をしないと永続的な視力障害が残ることもあります。3歳児検診や学校検診で引っかかったら、眼科を受診して精密な検査を受けて下さい。
・検診で異常が指摘されたら、早めに眼科受診をして下さい

